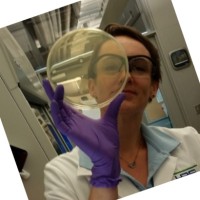
Allison Larson

Company Details
- Employees
- 3
- Founded
- -
- Address
- 5752 Oberlin Dr,
- Industry
- Environmental Services
- NAICS
-
Environmental Consulting Services
- Website
- http://www.h2omolecular.com
- Keywords
- water microbiology, microbial source tracking, digital PCR quantification, water reuse microbiology, recreational water quality, eDNA quantification, wastewater survillance, coliphage, fecal indicator bacteria, membrane filtration, multiplexing, assay design.
- HQ
- San Diego, CA